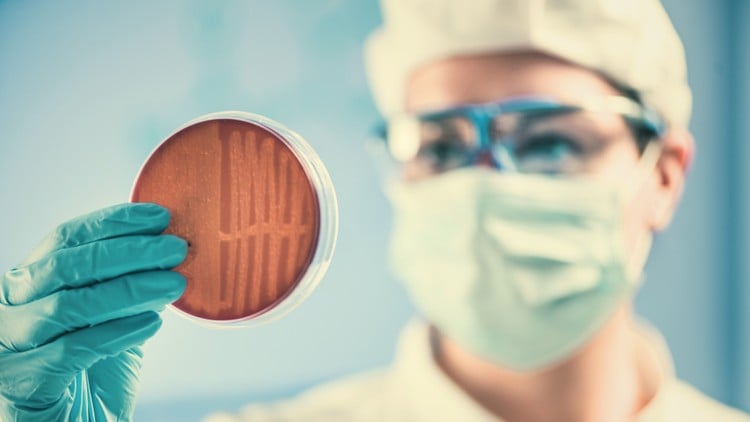
آموزش کنترل کیفیت میکروبی در داروسازی

آموزش پایتون پیشرفته برای تسلط IoT و یادگیری ماشین - آخرین آپدیت
دانلود Advanced Python for IoT and Machine Learning Mastery
به دوره "پایتون برای برنامه های IoT و یادگیری ماشین" خوش آمدید! در این برنامه جامع ، تقاطع برنامه نویسی پایتون را با برنامه های اینترنت اشیاء (IoT) بررسی خواهیم کرد و به قلمرو یادگیری ماشین می پردازیم. این دوره به منظور تجهیز شما به مهارت های اساسی و دانش مورد نیاز برای مهار قدرت پایتون برای ساخت راه حل های IoT و اجرای الگوریتم های یادگیری ماشین طراحی شده است.
در طول این دوره ، شما می توانید از اصول اولیه برنامه نویسی پایتون به موضوعات پیشرفته مانند برنامه نویسی سوکت ، ادغام پایگاه داده و یادگیری ماشین با کتابخانه هایی مانند Numpy سفر کنید. این که آیا شما یک مبتدی هستید یا یک توسعه دهنده با تجربه پایتون ، این دوره چیزی را برای همه ارائه می دهد ، شما را از طریق پروژه های دستی و تمرینات عملی برای تقویت یادگیری خود راهنمایی می کند.
تا پایان این دوره ، شما درک کاملی از چگونگی استفاده از پایتون برای توسعه برنامه های IoT ، برقراری ارتباط با دستگاه ها از طریق شبکه ها و اجرای مدل های یادگیری ماشین برای تجزیه و تحلیل داده ها و کارهای پیش بینی خواهید داشت. آماده شوید تا امکانات جدید را در IoT و یادگیری ماشین با پایتون به عنوان ابزار انتخاب خود باز کنید!
بخش 1: مقدمه
در این بخش مقدماتی ، دانش آموزان با مفهوم بسته ها و ماژول ها در پایتون آشنا می شوند. آنها می آموزند که چگونه بسته ها و ماژول ها سازمان کد ، قابلیت استفاده مجدد و قابلیت حفظ را تسهیل می کنند. اهمیت درک این مفاهیم پایه و اساس بقیه دوره را ایجاد می کند.
بخش 2: نصب
این بخش دانش آموزان را از طریق فرآیند نصب ابزارهای توسعه اساسی برای پایتون ، یعنی توزیع آناکوندا و Pycharm IDE راهنمایی می کند. آناکوندا توزیع جامع پایتون را با کتابخانه های از پیش نصب شده ارائه می دهد ، در حالی که Pycharm یک محیط توسعه یکپارچه قدرتمند را برای برنامه نویسی پایتون ارائه می دهد.
بخش 3: آجیل و پیچ ها
دانش آموزان در این بخش به جنبه های عملی برنامه نویسی پایتون می پردازند. آنها یاد می گیرند که چگونه برنامه ها را با استفاده از Pycharm اجرا کنند ، روش های مختلف لیست های پایتون را کشف کنند و ساختارهای اساسی و نحو کد پایتون را درک کنند.
بخش 4: مفاهیم شبکه سازی و شبکه سازی
این بخش دانشجویان را به مفاهیم اساسی شبکه در زمینه معماری مشتری-سرور معرفی می کند. آنها بینش در مورد ارتباط پیام بین مشتری و سرورها ، درک آدرس های IP سرور را درک می کنند و ملزومات پروتکل های شبکه را درک می کنند.
بخش 5: برنامه نویسی سوکت
دانش آموزان در مورد برنامه نویسی سوکت ، جنبه اصلی ارتباطات شبکه در پایتون می آموزند. آنها جنبه های برنامه نویسی ایجاد و مدیریت سوکت های شبکه ، نوشتن کد مشتری و سرور و استفاده از بسته های پایتون را برای اجرای چند رشته ای درک می کنند.
بخش 6: برنامه چت بابات
در این بخش ، دانش آموزان برای تهیه یک برنامه chatbot در یک پروژه عملی شروع می کنند. آنها یاد می گیرند که چگونه پیام ها را بین مشتری و سرورها ارسال و دریافت کنند ، منطق لازم را برای پاسخ های chatbot پیاده سازی کنند و ارتباطات مشتری-سرور را به طور مؤثر مدیریت کنند.
بخش 7: برنامه پایگاه داده و برنامه چت
دانش آموزان ادغام پایگاه داده ها را در برنامه Chatbot خود کشف می کنند. آنها در مورد مدیریت پایگاه داده با استفاده از PyCharm می آموزند ، دستورات SQL را برای ایجاد و دستکاری جداول درک می کنند و نمایش داده های پایگاه داده را برای بازیابی و تجزیه و تحلیل داده ها پیاده سازی می کنند.
بخش 8: عنصر مشتری و مجموعه داده ها
این بخش بر تجزیه و تحلیل مجموعه داده ها و کار با عناصر مشتری در برنامه Chatbot متمرکز شده است. دانش آموزان در مورد نمایه سازی عناصر مشتری ، برقراری ارتباط بین مشتری و سرورها و انجام وظایف تجزیه و تحلیل داده ها مانند تبدیل دما می آموزند.
بخش 9: Numpy
دانش آموزانبه کتابخانه Numpy معرفی می شوند ، که به طور گسترده برای محاسبات عددی در پایتون استفاده می شود. آنها در مورد مزایای استفاده از آرایه های NUMPY در لیست های پایتون می آموزند و عملیات و عملکردهای اساسی ارائه شده توسط کتابخانه را کشف می کنند.
بخش 10: آرایه های Numpy
در این بخش پیشرفته ، دانش آموزان عمیق تر به آرایه های Numpy و تکنیک های دستکاری آنها می پردازند. آنها یاد می گیرند که چگونه آرایه هایی از ابعاد مختلف ایجاد کنند ، عملیات برش را انجام دهند و عملیات ریاضی مختلفی مانند ضرب ماتریس و مقایسه عناصر را به کار گیرند.
مقدمه Introduction
-
آشنایی با بسته ها و ماژول ها Introduction to Packages and Modules
نصب Installation
-
مفهوم توزیع آناکوندا Concept of Anaconda Distribution
-
نصب Pycharm Installation of PyCharm
آجیل و پیچ Nuts and Bolts
-
اجرای برنامه ها در Pycharm Executing Programs in PyCharm
-
روش های لیست Methods of the List
-
یادگیری ساختار پیچ Learning the Bolt Structure
مفاهیم شبکه سازی و شبکه سازی Networking and Networking Concepts
-
جنبه شبکه سرور مشتری Networking Aspect of Client Server
-
ارتباط MESAAGE مشتری و سرور Mesaage Communication of Client and Server
-
IP سرور از مشتری به سرور Server IP from Client to Server
برنامه نویسی سوکت Socket Programming
-
جنبه برنامه نویسی شبکه Programming Aspect of Networking
-
نوشتن کد مشتری و سرور Writing the Client and Server Code
-
برنامه نویسی سوکت برای سرور Socket Programming for Server
-
بسته پایتون برای چند رشته ای Python Package for Multithreading
برنامه chatbot ChatBot App
-
کار با ربات چت Working with Chat Bot
-
ارسال و دریافت داده Sending and Receiving Data
-
کار روی سرور ربات چت Working on Chat Bot Server
-
ایجاد و وارد کردن سوکت مشتری Creating and Importing Client Socket
-
ایجاد پیام برای مشتری Creating Message for Client
-
یادگیری ایجاد یک برنامه چت Learning to Create a Chat App
برنامه پایگاه داده و چت Database and Chat App
-
پایگاه داده های Pycharm و SQLite Pycharm Databases and Sqlite
-
دستورات ایجاد یک جدول Commands for Creating a Table
-
درج مقادیر در جدول Inserting Values in Table
-
اتصال بین بانک اطلاعاتی و کد پایتون Connecting Between Database and Python Code
-
پرس و جو از پایگاه داده Query from Database
-
ایجاد تغییر در برنامه چت Making changes in Chat App
-
رمزگشایی اطلاعات مشتری Decoding the Client info
عنصر مشتری و مجموعه داده ها Client Element and Datasets
-
نمایه سازی عنصر مشتری Indexing the Client Element
-
اتصال از مشتری در آدرس Connection from Client at Address
-
افزودن ایمیل و نام مشتری Adding Email and Client Name
-
تجزیه و تحلیل مجموعه داده ها Analyzing the Data Sets
-
برنامه نویسی برای تبدیل وسوسها Coding for Converting Tempratures
-
تبدیل دما با استفاده از درک لیست Converting Temperature using List comprehension
اعماق Numpy
-
مقدمه ای برای Numpy Introduction to Numpy
-
اندازه لیست Size of List
-
حافظه مصرف شده توسط Ndarray Memory Consumed By Ndarray
-
لیست پایتون و آرایه های numpy Python List and Numpy Arrays
آرایه های numpy Numpy Arrays
-
ایجاد آرایه های numpy Creating Numpy Arrays
-
آرایه ابعادی مختلف در numpy Different Dimensional Array in Numpy
-
شکل یک آرایه Shape of an Array
-
قطعه قطعه Slicing
-
برش ادامه دهید Slicing Continue
-
آرایه ها و صفر Arrays of Ones and Zeros
-
نمونه Numpy Example
-
مثال numpy ادامه دهید Numpy Example Continue
-
با استفاده از scalers با آرایه های numpy Using Scalers with Numpy Arrays
-
ضرب ماتریس Matrix Multiplication
-
عملیات مقایسه Comparison Operations
https://donyad.com/d/599dd0
 EDU CBA
EDU CBA
مهارت های دنیای واقعی را بصورت آنلاین بیاموزید EDUCBA یک ارائه دهنده جهانی آموزش مبتنی بر مهارت است که نیازهای اعضا را در بیش از 100 کشور برطرف می کند. ما بزرگترین شرکت فناوری پیشرفته در آسیا با نمونه کارهای 5498+ دوره آنلاین ، 205+ مسیر یادگیری ، 150+ برنامه شغل محور (JOPs) و 50+ بسته دوره حرفه ای شغلی هستیم که توسط متخصصان برجسته صنعت آماده شده است. برنامه های آموزشی ما برنامه های مبتنی بر مهارت شغلی است که توسط صنعت در سراسر امور مالی ، فناوری ، تجارت ، طراحی ، داده و فناوری جدید و آینده مورد نیاز صنعت است.

نمایش نظرات